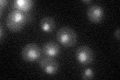
YNL103W
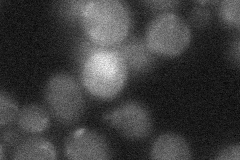
YNL103W
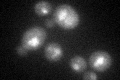
YNL103W
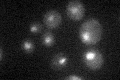
YNL103W

View description
Leucine-zipper transcriptional activator, responsible for the regulation of the sulfur amino acid pathway, requires different combinations of the auxiliary factors Cbf1p, Met28p, Met31p and Met32p
Localization:
Intensity:
Fold change:
Significance:
-
C’ GFP library in SD
nucleus26.57 -
N' NOP1pr-GFP in SD

nucleus30.2111 -
N' TEF2pr-mCherry in SD

nucleus201.587 -
N' NATIVEpr-GFP in SD

nucleus19.9304 -
N' TEF2pr-VC and Cyto-VN in SD
below threshold23.1708 -
C’ GFP library in SD+DTT
nucleus20.830.78No -
C’ GFP library in SD+H2O2

nucleus31.021.16No -
C’ GFP library in Starvation Media
nucleus22.530.84No -
C’ GFP library on the background of Pup2-DaMP

nucleus -
C’ GFP library on the background of CCT mutant

nucleus25.24660.949964No
